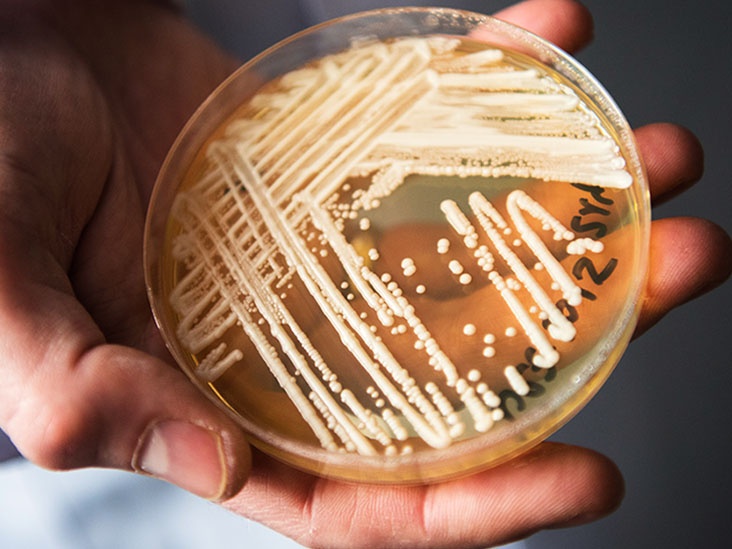

|
|
Bé gái 3 tuổi có kết quả dương tính với virus cúm và được kết luận là qua đời với các triệu chứng về đường hô hấp. Ảnh: iStock. |
Các quan chức ở Hạt Hidalgo, Texas, Mỹ, cho biết cái chết của bé gái 3 tuổi vào đầu tháng 10 có liên quan bệnh cúm. Đây là ca tử vong đầu tiên ở trẻ em vì bệnh cúm tại Mỹ trong năm 2022, theo dữ liệu của CDC.
Trước khi qua đời, em bé có kết quả xét nghiệm dương tính với virus cúm, kèm theo những triệu chứng về đường hô hấp.
Ngay khi đứa trẻ qua đời, các bác sĩ đã nghi ngờ bệnh cúm là thủ phạm gây ra cái chết. Song, theo thủ tục của chính quyền, các quan chức y tế bang phải xác minh trước khi đưa ra kết luận. Chính vì vậy, mất vài tuần, nguyên nhân cái chết của đứa trẻ mới được đưa ra.
Theo CDC, 39 ca tử vong ở trẻ em được báo cáo trong năm 2021-2022, nhưng con số thực tế có thể cao hơn nhiều. Cúm là bệnh đường hô hấp do virus họ cúm gây ra. Căn bệnh này dễ lây lan và gây ra các triệu chứng như ho, đau họng, đau nhức cơ thể và sốt.
Theo một báo cáo của CGI Health, thung lũng Rio Grande là khu vực nóng nhất trên toàn nước Mỹ với làn sóng cúm bùng phát mạnh mẽ. Đại diện Cơ quan Y tế Quận Cameron, tiến sĩ James Castillo, cho biết bệnh cúm gần như không hoạt động trong 2 năm nhờ các biện pháp phòng dịch Covid-19. Tuy nhiên, làn sóng gia tăng các ca mắc cúm và cả số ca nhập viện đang được ghi nhận ở nhiều nơi.
Theo The Hill, nó không chỉ giới hạn ở Nam Texas mà khắp nước Mỹ. Quan chức khuyến cáo trẻ em và người lớn nên ở nhà khi mắc bệnh, đeo khẩu trang và rửa tay để ngăn chặn sự lây lan của virus cúm.
Ngoài ra, tất cả người dân từ 6 tháng tuổi trở lên cần được tiêm phòng vaccine cúm, bất kể tình trạng sức khỏe của họ như thế nào. Đây là cách hữu hiệu để phòng các biến chứng nguy hiểm mà căn bệnh này gây ra.